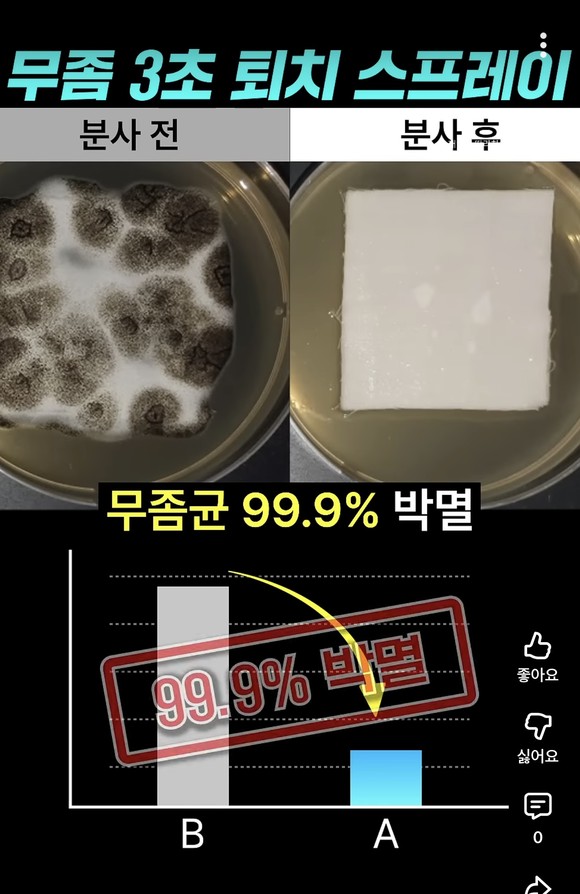

[이슈] ‘AI 가짜 의사’에 속지마세요…유튜브 허위·과장 광고, 시장 전반으로 확산
가상 인물들이 전문가 행세하며 제품 효능 과장…소비자 오인 우려 커져
 한시영⁄ 2025.11.11 10:09:55
한시영⁄ 2025.11.11 10:09:55

AI 기술이 상업 광고에 빠르게 활용되며 실제 존재하지 않는 가상의 인물이 ‘전문가’나 ‘의사’를 자처해 제품 효능을 설명하는 영상이 확산되고 있다. 마치 전문가의 조언처럼 꾸며진 영상 속에는 근거가 불분명한 내용이 반복돼 소비자들이 이를 사실로 받아들이기 쉽다는 우려가 제기된다. 이 같은 양상은 식품을 시작으로 공산품과 생활용품 등 다양한 제품군으로 확대되며 허위·과장 광고의 범위가 시장 전반으로 커지고 있다.
유튜브 AI 전문가, ‘필수 섭취’ 강조…실상은 일반식품

최근 유튜브 등 소셜 미디어에서는 가상의 인물이 의사나 전문가로 등장해 특정 성분의 효능을 과장하거나 검증되지 않은 정보를 전달하는 영상이 잇따라 공개되고 있다. 일부 영상에서는 AI로 생성된 인물이 실제 의료 전문가인 것처럼 연출돼, 성장인자나 특정 성분의 섭취를 필수로 강조하기도 한다.
한 영상에서는 AI로 제작된 남성이 “키 성장이 180cm도 가능하다”, “효과는 엄청나지만 부작용은 없다” 등 제품 효능을 암시하는 발언을 반복했다. 해당 제품은 일반식품으로 분류되며, 식품의약품안전처(식약처)가 인정한 기능성 원료를 함유하지 않은 것으로 확인됐다.
식약처는 일반식품 기능성표시제를 통해 건강기능식품이 아니더라도 고시된 기능성 원료를 사용한 제품의 경우에만 ‘키 성장에 도움’ 등의 표시를 허용하고 있다. 그러나 기능성 원료 없이 성장 효과를 내세운 광고가 잇따르며, AI 광고를 활용한 허위·과장 행위에 대한 관리 강화가 필요하다는 지적이 나온다.
주름 개선·리프팅 효과 강조…알고 보니 ‘공산품’

식품 광고에 이어, 공산품 분야에서도 AI를 활용한 영상 광고가 빠르게 늘고 있다. 일부 영상에서는 가상의 인물이 의사나 전문가로 등장해 팔자주름 개선이나 하관 리프팅 등 미용 효과를 강조한다.
특히 한 영상에서는 남성이 ‘팔자주름 리프터’를 소개하며 “하관이 안면거상 한 듯 올라붙는다”, “안면거상술과 효과가 약 97% 비슷하다”는 식으로 수술과 유사한 수준의 효과를 내세웠다. 하지만 해당 제품은 의료기기나 화장품이 아닌, 전기·전자 기능을 이용해 작동하는 단순 공산품인 것으로 확인됐다.
공정거래위원회의 표시광고법에 따르면, 공산품 등 일반 제품이 근거 없이 효능이나 효과를 단정적으로 표현하는 광고는 금지돼 있다. 그럼에도 미용 시술에 준하는 효과를 내세우는 사례가 늘면서, 공산품 광고에 대한 허위·과장 표현 관리 강화가 필요하다는 지적이 나온다.
생활용품·의약외품 광고…‘질병 개선’ 효과 암시
생활용품과 의약외품 광고에서도 과장된 효능을 내세우는 사례가 잇따르고 있다. 일부 영상은 AI 이미지나 내레이션 편집을 활용해 의약품으로 오인될 만한 표현을 사용하고 있다
한 유튜브 영상에서는 신발 탈취제를 소개하며 ‘무좀 3초 퇴치’, ‘무좀균 99.9% 박멸’ 등 살균효과를 단정적으로 내세웠다. 분사 전후 비교 화면과 그래프를 함께 제시해 실제 의학적 효능이 입증된 것처럼 연출한 것이다. 그러나 환경부가 고시한 ‘생활화학제품 표시·광고 가이드라인’에 따르면, 세정제·탈취제·소독제 등 화학성분을 사용한 제품이 질병의 치료나 예방 효과를 내세워 광고하는 행위는 명백한 법 위반으로 규정된다.
또 다른 영상에서는 무좀 치료제를 홍보하며 “환자 한 분은 사용 후 완치됐다”는 등 소비자가 의약품 수준의 효능을 기대할 수 있는 문구를 사용했다. 해당 제품은 질병 치료 목적의 의약품이 아니라, 살균·소독 등 위생을 목적으로 하는 의약외품으로 분류된다. 식약처는 가이드라인을 통해 의약외품 광고에서 품질이나 효능을 객관적으로 입증하기 어렵거나 의약품으로 오인될 우려가 있는 표현을 금지하고 있다.
전문가들은 “AI를 활용한 영상 광고는 식별이 어렵고 확산 속도도 빠르지만, 플랫폼의 사전 필터링 체계가 사실상 전무하다”며, “플랫폼 사업자에게도 일정한 책임을 부과하는 제도 개선이 필요하다”고 지적했다. 실제 유튜브 등 대형 플랫폼은 광고주가 아닌 ‘매개자’라는 이유로 책임을 회피하고 있어 허위·과장 광고 확산의 구조적 원인으로 꼽힌다.
식품의약품안전처 관계자는 “AI로 제작된 가짜 의사가 등장하는 광고는 소비자의 올바른 제품 인식을 방해하고 의료 전문가 직역의 신뢰를 떨어뜨릴 우려가 크다”며 “관련 제보가 접수되면 사실 여부를 확인해 사이트 차단이나 현장 조사 등 필요한 행정 조치를 취할 계획”이라고 말했다.
<문화경제 한시영 기자>
- 관련태그
- AI 유튜브 약광고 건강기능식품 허위광고



































